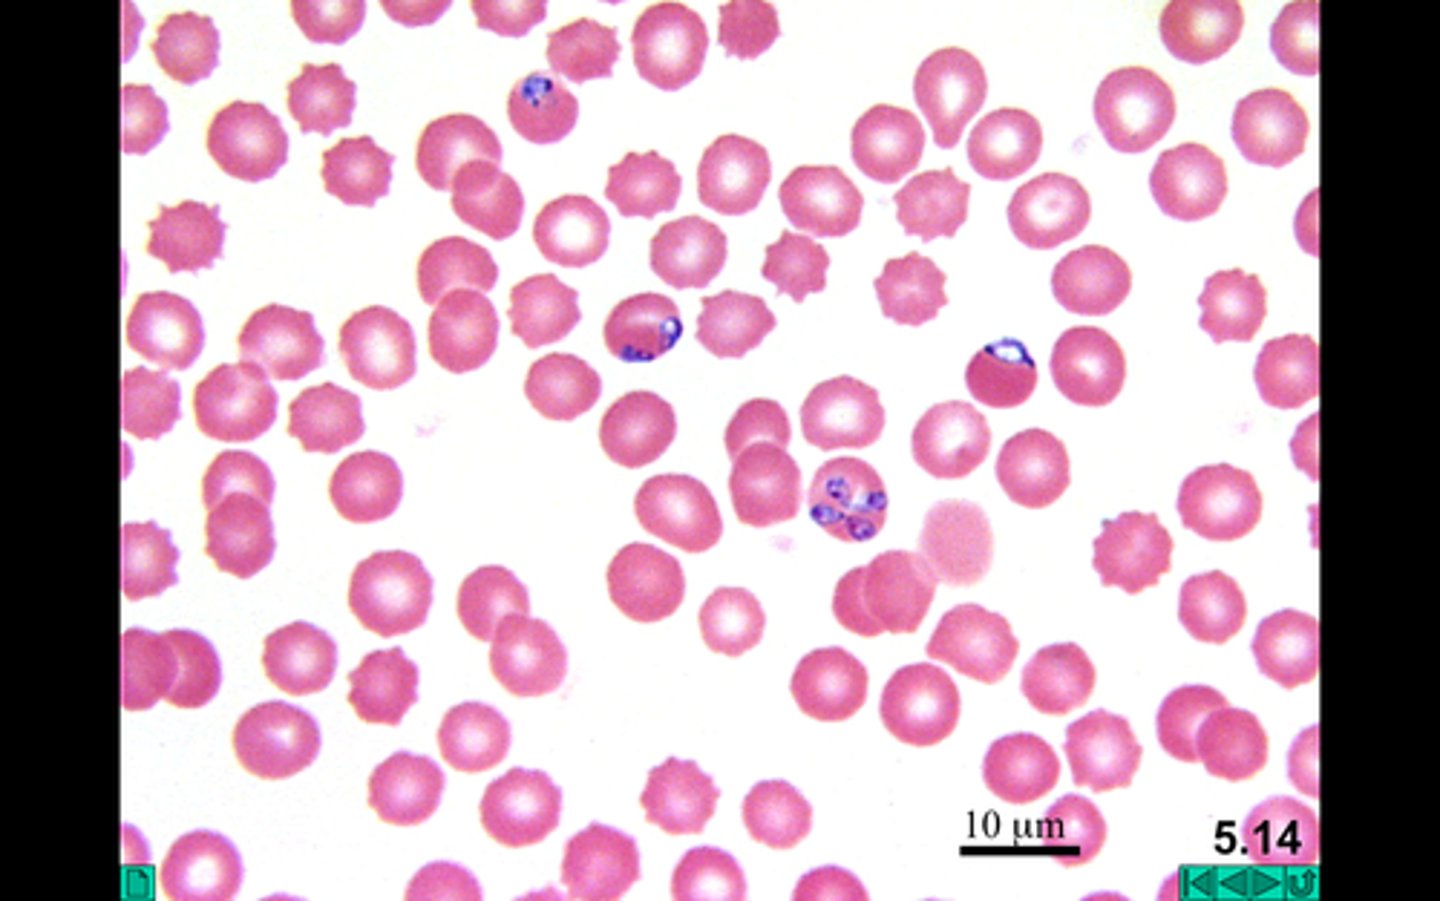
<p>- Single-celled</p><p>- Parasite</p><p>- Intracellular (Inside host)</p><p>- Causes malaria</p><p>- Non-motile</p><p>3 multiple choice options</p>

WSU BIO 1501 Chapter 10: Protists
1/39
There's no tags or description
Looks like no tags are added yet.
Name | Mastery | Learn | Test | Matching | Spaced | Call with Kai |
|---|
No analytics yet
Send a link to your students to track their progress
40 Terms
Protists
- Eukaryotic organisms that are not plants, animals, or fungi.
- Can be single-celled, multicellular, or colonial
- Wide range of feeding methods, movement, and reproduction
- Not a monophyletic group
3 multiple choice options

Monophyletic Group
A group of organisms that consists of a single common ancestor and all of its descendants
2 multiple choice options
What are the 6 supergroups in Eukarya
- Excavata
- Chromaveolata
- Rhizaria
- Archeplastida
- Amoebazoa
- Opisthokonta
2 multiple choice options
Unicellular
Consists of a single cell, within which all life processes necessary for survival
3 multiple choice options

Multicellular
A living being that is made up of more than one cell, with these cells typically organized into specialized tissues, organs, and organ systems
3 multiple choice options

Colonial
Genetically identical cells that live together in close association, often for mutual benefit, but retain individual function
3 multiple choice options

What species is this, and what is its body plan?
Amoeba, single celled
3 multiple choice options

What species is this, and what is its body plan?
Diatom(s), single celled
3 multiple choice options

What species is this, and what is its body plan?
Slime Molds, colonial
3 multiple choice options

What species is this, and what is its body plan?
Volvox, colonial
3 multiple choice options

What species is this, and what is its body plan?
Red Algae, multicellular
3 multiple choice options

Plant-Like Protists
- Commonly known as algae
- Contain chloroplasts
- Are autotrophic (photosynthetic)
- Lack specialized tissues and organ systems
- They are important in marine and aquatic environments food chains
3 multiple choice options

Fungi-Like Protists
- Heterotrophs that feed on decaying matter (detritivores)
- Reproduce via spores
3 multiple choice options

Animal-Like Protists
- Commonly known as Protozoa
- Are heterotrophic
- Consume other organic matter
- Usually motile with appendages to help movement
3 multiple choice options

Volvox
- Phylum Chlorophyta
- Asexual reproduction
- Colonial Body Plan
- Motile via flagellum
3 multiple choice options

Spirogyra
- Ladder-like
- Sexual reproduction via conjugation
- Multicellular
- Not motile
3 multiple choice options

Conjugation
Genetic transfer between bacteria through physical contact
3 multiple choice options

Diatoms
- Phylum Bacillariophyta
- Single celled body plan
- Photosynthetic
- Silica in test (shell)
- Not motile
- Asexual reproduction by binary fission
3 multiple choice options

Phylum Rhodophyta
- Commonly known as Red Algae
- Plant like
- Phycoerythrin pigment for photosynthesis
- Multicellular or colonial
- Not motile, only gametes are
- Alternation of generation life cycle
3 multiple choice options

Euglena
- Phylum Euglenophyta
- Single celled body plan
- Mixotrophic, photosynthetic and ingestion
- Flexible pellicle coating
- Motile via a flagella
- Light-sensitive eyespot
3 multiple choice options

Phylum Myxomycota
- Fungus like
- Plasmodial
- Cytoplasmic/protoplasmic streaming
- Reproduction via spores and fruiting bodies
3 multiple choice options

Plasmodial
Multinucleated cell (supercell), lack of cell membranes between nucleus, and is mobile
3 multiple choice options

Amoeba
- Phylum Rhizopoda
- Single cell body plan
- Phagocytosis (Food particles)
- Psuedopodia (Fake feet for movement)
- Cytoplasmic streaming
3 multiple choice options

Forams
- Look like sea shells
- Phylum Foraminifera
- Unicellular
- Calcium carbonate in test (shell)
- Psuedopodia extend out for feeding
3 multiple choice options

Trypanosoma
- Pathogenic diseases
- Unicellular
- Flagellum, motile
- Zooflagillate
- African Sleeping Disease, and Chagas Disease
3 multiple choice options

Trichomonas Vaginalis
- Zooflagillate
- Parasite
- Flagellum, motile
- Common STI, humans are only known host
3 multiple choice options
Zooflagillate
Any heterotrophic, animal-like protist that possesses one or more flagella for movement
3 multiple choice options
Ciliates
- Phylum Ciliophora
- Many different shapes
- Known for motile appendages called cilia
3 multiple choice options

Paramecium
- Phylum Ciliophora
- Unicellular
- Heterotrophic
- Reproduc via binary fission
- Conjugation during reproduction
- Cilia for movement and feeding
- Long oval shape
3 multiple choice options

Phylum Apicomplexa
- Single-celled
- Parasite
- Intracellular (Inside host)
- Causes malaria
- Non-motile
3 multiple choice options
Toxoplasma Gondii
- Unicellular
- Intracellular (Inside host)
- Parasite
- Reproduces sexually in cat intestines
- Harmful to human fetuses
3 multiple choice options

Which of the following characteristics is common to all protists?
They are eukaryotic
3 multiple choice options
Euglena is an example of a mixotroph. What does this mean?
It can switch between photosynthesis (autotrophy) and consuming other organisms (heterotrophy)
3 multiple choice options
To which group of protists do the large, multicellular seaweeds and kelps belong?
Brown Algae (Phaeophyta)
3 multiple choice options
Which specialized structure do amoebas use for movement and feeding?
Pseudopodia
3 multiple choice options
The intricate, glass-like cell walls of diatoms are made primarily of which substance?
Silica
3 multiple choice options
The protist responsible for causing malaria in humans is a non-motile parasite belonging to what genus?
Plasmodium
3 multiple choice options
What is the primary difference in cell wall composition between fungus-like protists (like water molds) and true fungi?
Fungus-like protists use cellulose; true fungi use chitin
3 multiple choice options
The process of cytoplasmic streaming in large protists and plant cells serves what primary purpose?
To rapidly distribute nutrients, waste products, and organelles throughout the cell
3 multiple choice options
Volvox is studied as a model organism because its hollow, spherical colonies show early signs of?
Cell specialization (division of labor)
3 multiple choice options